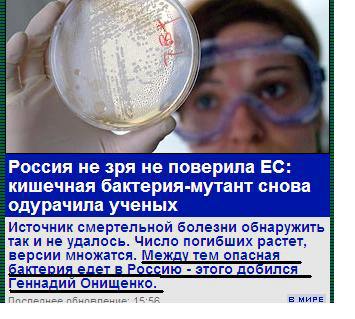

Складные трояны детских горелок
Журналисты - они такие смешные, веселится Павел.

***
Складная металлическая мебель, замечает Галина, с успехом заменит плед, надувной матрац, бутылку водки и батон колбасы. Вот такая вот волшебная конструкция.

***
Суровые суданские СМИ, ужасается Антон, разбили уже просто последних. Скоро разбивать некого останется.

***
"Яндекс" - такой шалун, восхищается Марат К.

ЗАО "Игротехника", замечает Михаил, тоже большие шалуны. Ведь под одеялом можно такие игры замутить...

***
Если у вас есть автомобиль ВАЗ, советует Эдуард, приобретите инструмент для его ремонта.

***
От иных горелок, замечает Андрей, уж дух захватывает и начинаешь говорить нечлено... нечлено... нечленоразделенно.

***
Производить-то она производит, грустит Geri ben Sander, вот только куда эти квадрильоны потом девать...

***
Теперь хоть понятно, замечает Алексей, что отвечать ребенку на вопрос, откуда берутся дети.

***
Прекрасное название для магазина, считает SokoLOVE.

Зато там все строго по алфавиту!

***
Приятно, замечает Дмитрий, что МВД умеет выражать свои мысли четко и лаконично.

***
Это называется, замечает Алина, найти гармонию с самим собой.

***
Какой прекрасный анонс, замечает Денис. Надо бы посмотреть, интересное кино.

***
Молодцы, предприниматели, восхищается Дмитрий. Вовремя подсуетились!

***
Странно как-то написано, считает Вадим. Должно быть написано "толговыми палтнелами".

***
Главное в некрологе - лаконичность, считает PBrush.

***
Заслуги Онищенко трудно переоценить, считает RocUA.
***
"Яндекс" обнаружил на улицах Новосибирска загадочное явление - двухколесный автомобиль, рассказал Максим.

А что, экономичная моделька. Зимней резины надо сразу в два раза меньше.
Свои баннизмы присылайте сюда, спасибо.
Вот, и я хотел о том же написать! Киянка - это нормальный инструмент для выравнивания корпуса машины.
neverdie
Вот, о чем я и говорю!
А в чем прикол со складной мебелью? - спрашивает Dyadka4.
Отвечаю. Главный прикол в том, что ИКЕЯ - это вообще не мебель, а набор досок, которые хрен соберешь.
У меня один друг собрал так из досок тумбочку под телевизор, а потом его жена прочла в инструкции, что это СТУЛ!
Тут вот в чём фишка. Допустим, я на пикнике найду пустой тазик, переверну его и буду на нём сидеть. Следует ли в таком случае писать, что складной походный стульчик отличная замена тазику?
То, что тазик - замена стульчику - звучит более логично, но все равно этого нельзя сказать.
"Яндекс" обнаружил на улицах Новосибирска загадочное явление - двухколесный автомобиль, рассказал Максим.
Речь же про пикник - там сначала сидят на пледе и пьют, а потом лежат на надувном матраце и спят! 😄
А в чем прикол со складной мебелью?
Речь же про пикник - там сначала сидят на пледе и пьют, а потом лежат на надувном матраце и спят!
В том, что падежи перепутали, похоже. Плед и матрас заменяют металлическую мебель, а не наоборот, я думаю.
А в чем прикол со складной мебелью?
Ну как, мало того, что предлагают вместо матраца лежать на железке, так ещё и вместо пледа укрываться ею же. Падежи перепутаны, и смысл предложения сменился на противоположный.
А в чем прикол со складной мебелью?
Речь же про пикник - там сначала сидят на пледе и пьют, а потом лежат на надувном матраце и спят!
Тут вот в чём фишка. Допустим, я на пикнике найду пустой тазик, переверну его и буду на нём сидеть. Следует ли в таком случае писать, что складной походный стульчик отличная замена тазику?
Киянка - это не для ремонта, это для автомобильной красоты
Инструмент для мотивации механика в автосервисе 😄
Экслер, возвращайся уже на родину - тут Яндекс во всю в оффлайне рекламирет свои яндекс-карты несуразными сочетаниями улиц и заведений. Типа "пицца гороховая" (подразумевая пиццерии на улице Гороховая), "бижутерия на крупской", "зоомагазин академика павлова", "салон красоты металлистов" (это всё топонимы по Питеру).
А в Москве имеются "колготки юных ленинцев" (это, я считаю, зе бест!), "компьютер малый дровяной", "парики льва толстого", "турагенство декабристов".
Так что это, в общем-то, не баннизм никакой. А хороший здоровый креатив маркетологов яндекса.
 
                         
                     
                     
                     
                     
                    